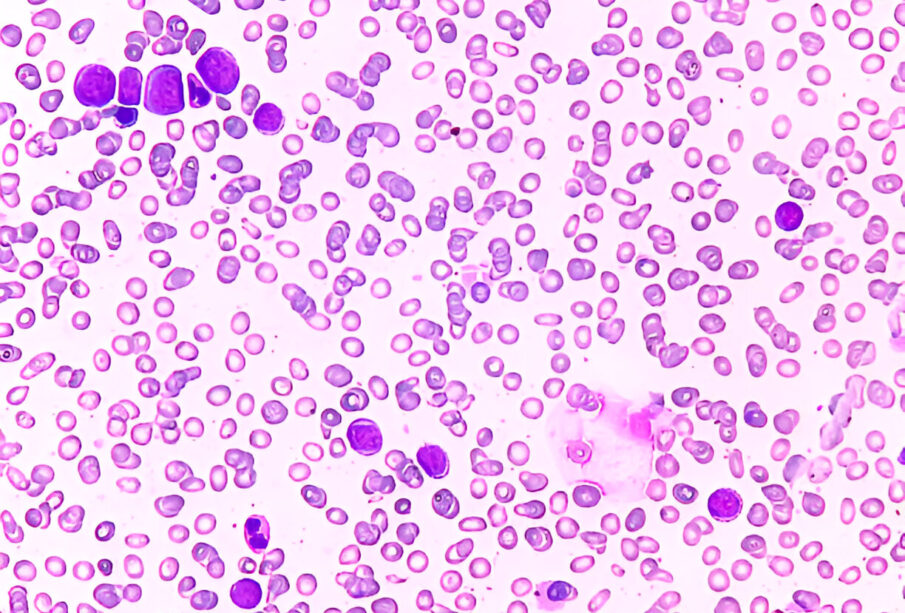
Padidėjęs eozinofilų kiekis kraujyje

Αυξημένος αριθμός ηωσινόφιλων στο αίμα: Συμπτώματα και αντιμετώπιση
Θα μάθετε
- Τι προκαλεί αύξηση των ηωσινόφιλων;
- Ποια είναι τα συμπτώματα αυξημένων ηωσινόφιλων;
- Παθήσεις που σχετίζονται με την αυξημένη παρουσία ηωσινόφιλων
- Τι σηματοδοτεί η αύξηση των ηωσινόφιλων;
- Τι υποδηλώνει χαμηλό επίπεδο ηωσινόφιλων;
- Πώς γίνεται η διάγνωση αυξημένων ηωσινόφιλων;
- Ποιες είναι οι διαθέσιμες θεραπείες για αυξημένα ηωσινόφιλα
- Πώς μπορεί να προληφθεί η αύξηση των ηωσινόφιλων
Η ηωσινοφιλία είναι μια κατάσταση των λευκών αιμοσφαιρίων που χαρακτηρίζεται από αυξημένα επίπεδα ηωσινόφιλων στο αίμα. Η αιτία μπορεί να ποικίλει, από αλλεργική ρινίτιδα μέχρι σοβαρότερες παθήσεις όπως οι κακοήθειες. Η διάγνωσή της γίνεται συνήθως μέσω αιματολογικών εξετάσεων, όπου ανιχνεύεται ο υψηλός αριθμός ηωσινόφιλων. Τα ηωσινόφιλα αποτελούν σημαντικό μέρος της άμυνας του οργανισμού και συμβάλλουν στις φυσιολογικές λειτουργίες του ανοσοποιητικού συστήματος. Η διάγνωση επιβεβαιώνεται όταν ανευρίσκονται περισσότερα από 500 ηωσινόφιλα ανά μικρολίτρο αίματος, αν και το όριο μπορεί να διαφέρει ανάλογα με τις οδηγίες. Σε φυσιολογικές συνθήκες, τα ηωσινόφιλα αντιστοιχούν σε λιγότερο από 5% όλων των κυκλοφορούντων λευκών αιμοσφαιρίων.
Τι προκαλεί αύξηση των ηωσινόφιλων;
Η αύξηση των επιπέδων των ηωσινόφιλων μπορεί να προκληθεί από διάφορους παράγοντες, όπως οι παρακάτω:
- Εποχικές αλλεργίες
- Άσθμα
- Ανεπιθύμητες αντιδράσεις σε φαρμακευτικές ουσίες
- Λοιμώξεις από παράσιτα
Επιπρόσθετα, διαταραχές της αυτορρύθμισης του ανοσοποιητικού, συμπεριλαμβανομένων αυτοάνοσων νοσημάτων όπως τα παρακάτω, μπορούν να επηρεάσουν τα επίπεδα των ηωσινόφιλων:
- Φλεγμονώδεις παθήσεις του εντέρου
- Αυτοάνοση μυοκαρδίτιδα
- Αγγειίτιδες
- Σαρκοείδωση
- Κακοήθειες του αιμοποιητικού συστήματος
- Κληρονομικές μεταλλάξεις στο γενετικό υλικό
Ποια είναι τα συμπτώματα αυξημένων ηωσινόφιλων;
Τα κλινικά σημεία που μπορεί να εμφανιστούν όταν τα ηωσινόφιλα είναι αυξημένα περιλαμβάνουν:
- Δερματικά εξανθήματα
- Φαγούρα
- Διάρροια, που είναι πιο συχνή σε παρασιτικές λοιμώξεις
- Συμπτώματα άσθματος
- Καταρροή, ιδιαίτερα σχετιζόμενη με αλλεργίες
- Επίμονος βήχας με ηωσινοφιλικό χαρακτήρα
Παθήσεις που σχετίζονται με την αυξημένη παρουσία ηωσινόφιλων
Όταν η παρουσία ηωσινόφιλων προκαλεί φλεγμονώδη αντίδραση σε συγκεκριμένα όργανα, μπορεί να εμφανιστεί είτε ηωσινοφιλική νόσος είτε υπερηωσινοφιλικό σύνδρομο. Οι καταστάσεις αυτές μπορούν να επηρεάσουν διάφορα συστήματα του οργανισμού, όπως την ουροδόχο κύστη, το δέρμα, τους πνεύμονες και την καρδιά. Άλλες διαταραχές που συσχετίζονται με υψηλά επίπεδα ηωσινόφιλων περιλαμβάνουν:
- Ηωσινοφιλική κυστίτιδα, μια φλεγμονή που αφορά την ουροδόχο κύστη
- Ηωσινοφιλική πνευμονία, όπου οι πνεύμονες προσβάλλονται από τα αυξημένα ηωσινόφιλα
- Ηωσινοφιλική φακίτιδα, προσβάλλοντας τους συνδετικούς ιστούς που περιβάλλουν μύες και όργανα
- Ηωσινοφιλικές παθήσεις του πεπτικού, όπως ηωσινοφιλική οισοφαγίτιδα, στομαχικές διαταραχές, παθήσεις του λεπτού και παχέος εντέρου
- Ηωσινοφιλική κοκκιωματώδης αγγειίτιδα με πολυαγγειίτιδα, επίσης γνωστή ως σύνδρομο Churg-Strauss, η οποία μπορεί να επηρεάσει καρδιά, πνεύμονες και άλλα όργανα
Τι σηματοδοτεί η αύξηση των ηωσινόφιλων;
Η μέτρηση του απόλυτου αριθμού ηωσινοφιλικών κυττάρων αποτελεί βοηθητικό εργαλείο για τη διάγνωση διαφόρων παθήσεων. Αυξημένα επίπεδα ηωσινόφιλων μπορούν να παρατηρηθούν στις παρακάτω περιπτώσεις:
- Οξεία υπερηωσινοφιλικά σύνδρομα
- Aλλεργικές παθήσεις, όπως το άσθμα ή εμπύρετες καταστάσεις
- Αυτοάνοσες διαταραχές
- Ανεπιθύμητες παρενέργειες φαρμάκων
- Πρώιμα στάδια της νόσου Cushing
- Έκζεμα, δηλαδή ερεθισμένο και φαγούρα δέρμα
- Λευχαιμίες και άλλες αιματολογικές κακοήθειες
Τι υποδηλώνει χαμηλό επίπεδο ηωσινόφιλων;
Μειωμένη συγκέντρωση ηωσινοφιλικών κυττάρων μπορεί να αποδοθεί σε παράγοντες όπως:
- Υπερβολική κατανάλωση αλκοόλ
- Πλεονάζουσα παραγωγή συγκεκριμένων στεροειδών ουσιών από τον οργανισμό, όπως η κορτιζόλη
Πώς γίνεται η διάγνωση αυξημένων ηωσινόφιλων;
Ο εντοπισμός αυξημένων ηωσινόφιλων επιτυγχάνεται συνήθως μέσω της ανάλυσης αίματος. Ανάλογα με τα ευρήματα, ο γιατρός μπορεί να συστήσει περαιτέρω εξετάσεις για να διερευνηθούν τα πιθανά αίτια. Σε περιπτώσεις που υπάρχουν συμπτώματα από το πεπτικό σύστημα, η διερεύνηση περιλαμβάνει λήψη αναλυτικού ιστορικού, ανάλυση των συμπτωμάτων και διαγνωστικές εξετάσεις στο γαστρεντερικό.
Ποιες είναι οι διαθέσιμες θεραπείες για αυξημένα ηωσινόφιλα
Οι θεραπευτικές επιλογές για την ηωσινοφιλία μπορεί να περιλαμβάνουν τα εξής:
- Διακοπή συγκεκριμένων φαρμακευτικών σκευασμάτων ή αποφυγή τροφών, ανάλογα με την αιτία
- Χορήγηση φαρμάκων που καταστέλλουν τη φλεγμονή ή καταπολεμούν μικροβιακούς παράγοντες
- Διερεύνηση θεραπευτικών επιλογών για άλλες ηωσινοφιλικές παθήσεις
- Η έκβαση εξαρτάται από την αντιμετώπιση του βασικού αιτίου και την ανταπόκριση στη θεραπεία
Πώς μπορεί να προληφθεί η αύξηση των ηωσινόφιλων
Η ηωσινοφιλία που προκύπτει από αλλεργίες μπορεί να ελεγχθεί με τη χρήση ειδικής φαρμακευτικής αγωγής για τη μείωση των αλλεργικών συμπτωμάτων. Παρ’ όλα αυτά, η αύξηση ηωσινόφιλων μπορεί κάποιες φορές να αποτελεί ένδειξη σοβαρότερου προβλήματος υγείας που απαιτεί άμεση ιατρική παρέμβαση. Για την ελαχιστοποίηση του κινδύνου, συνίσταται να λαμβάνονται προληπτικά μέτρα, όπως:
- Αποφυγή κατανάλωσης ωμής ψαριού, κρέατος, σαλιγκαριών, γαρίδων και άλλων θαλασσινών
- Καλή πλύση των φρούτων και λαχανικών ώστε να απομακρύνονται τυχόν παράσιτα
- Διατήρηση καθαρού περιβάλλοντος για περιορισμό αλλεργιογόνων και μολυσματικών παραγόντων
- Αποφυγή χρήσης φαρμάκων που προκαλούν ανεπιθύμητες αλλεργικές αντιδράσεις









